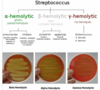

Bacterial CNS Flashcards
(40 cards)
what are the types of hemolysis?
- alpha
- green, aka partial hemolysis
- alpha hemolysin partially breaks down RBC, the culture is clear
- beta
- culture apears clear
- breaks down the RBC and hemoglobuin entirely
- gamma
- the culture just has the growth with out any color change
- does not contain hemolysin
gram negative rods
nonmotile
facultative anaerobes
- oxidase?
- catalase?
- required growth factors?
haemophilus influenzae
- gram negative rods
- non-motil
- facultative anearobes
- oxidase +
- catalase +
- reduce nitrates
- require preformed growth factors
- X(hemin)
- V(NAD)
invade bloodstream by breakdown in the tight junctions between epithelial cells
describe the significant subtype.
haemophilus influenza B
- type b
- encapsulated strain capable os sytemic invasion
- HiB = vaccine against this strain
what are the virulence factors for HiB?
- virulence
- capsule
- most important factor
- IgA proteases
- fimbriae adherance
- LPS- via gram negative rod
- capsule
strict human pathogen
- O2 use
- gram
- culture
- important features
neisseria meningitidis
- aerobic, nonmotile, non-spore forming
- gram negative, diplococci
- chocolate agar
- importantt features
- catalase +
- capnophilic- requires CO2
- requires iron-possible reason for being strict human pathogen
- competes with human host by binding human transferrin
what are the virulence factors for neisseria meningitidis?
- pili (fimbriae)
- capsule
- transferin - receptor for iron
- endotoxin - gram - LPS
- IgA protease
transmission from respiritory dropletts, found on mucosal surfaces of nasohparynx and oropharynx
neisseria meningitidis
meningitidis in children and infants
HiB
meningitidis found in every age group
Neisseria meningitidis
purpura of skin and mucous membranes
petechial rash
DIC
these are all symptoms of meningococcemia

meningitidis from organism that colonizes the nasopharyngeal mucosa
neisseria meningitidis
neisseria meningitidis meningisums include (3)
meningismus
- inflammation of the meninges or subarachnoid hemorrhaging
- nuchal rigidity
- kernigs sign, brudzinskis sign
altered sensorium- cannot think clearly
Gram + diplococci
- hemolytic
- catalase
- oxidase
- urease
- ferments

list two important species taht are catalase + and -

key virulence factor for invasive streptococcus pneumoniae
polysaccharide capsule
most common cuase of meningitis in adults, second most common cause in children.
transmission through respiratory droplets.
- gram
- hemolysis
- catalase
- Ab sensitive test
- urease
- ferments
streptococcus pneumoniae

What does the protease of the following target
- HiB
- N. meningitidis
- S. pneumonia
IgA
- prblems is the potential of inhibiting beneficial effects of IgG Ab
- PCR diagnostic assay
- require low number of sample to detect bacteria
patient presents to the ER 11 days after eating some ice cream, which was later found to be recalled.
The bacteria was sampled and found to grow on blood agar.
- bacteria
- gram
- O2 demand
- Catalse
- Oxidase
- derived from

CNS invasion of lysteria monocytogenes includes
- BBB
- WBC
- oral mphage
- taken up by phagocytosis and can exit the cell and enter the surrounding enviornment. This is an issue if this happens while the cell is in the brain or near.
- CNS invasion by one of the three methods
- invasion of the endothelial cells of the BBB
- transportation of bacteria to the CNS within circulating leukocytes
- phagocyte facilitated
- bacteria inoculated into oral tissues through chewing of contaminated food
- followed by macrophage phagocytosis which in turn can invade cranial nerves
fifth most common cause of meningitis
- risk groups

bacitracin resistant
catalase negative
- gram
- hemolysis
- virulence factors-3
streptococcus agalactiae
- gram +
- beta hemolysis
- virulence
- capsule
- pore forming bet heolysin/cytolysin
affects neonates, infants and older than 60.
gram +
bacitracin resistant
catalase negative
streptococcus agalactiae
how many samples are collected and for who on a CSF analysis
- 4 samples
- chemistry/serology
- microbiology
- hematology
- differential
- immunological test/protein electrophersis
How does glucose level in CSF analysis affect the following and what does it indicate? -3
- increase WBC + neutrophils a +decreased CSF glucose
- bacterial meningitis
- increased WBC + lymphcytes + decreased CSF glucose
- tubercular meningitis
- increased WBC + lymphocytes + normal CSF glucose
- viral meningitis



